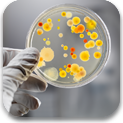

San Diego Indoor Air Quality Testing & Inspections
We are here to assist you in resolving today's indoor environmental problems and concerns. We can help you by preventing future issues through our innovative approaches and practical cost effective solutions. ET&T has served the Southern California community since 1986 and has worked with thousands of businesses, home owners, physicians, insurance companies, law firms, hospitals and government agencies from San Diego to the Bering Sea.
Our team of highly experienced, licensed and certified professionals will serve you with our state of the art instrumentation. We utilize on-site diagnostic devices to screen for different chemicals, biological agents, particles, pressure differentials, gases, electromagnetic fields and radiation. If your needs exceed our in house laboratory's capabilities, we seek assistance from the most appropriately qualified and accredited analytical laboratories available. ET&T has also established a network of affiliated experts throughout the United States, Canada and Europe to satisfy your project needs.
ET&T has been a leader in Indoor Air Quality (IAQ) surveys and provided the first commonly available mold testing/consulting service in Southern California for residential and commercial buildings.
"Our Mission is to Detect and Protect!" - Peter Sierck, President
To speak with an Indoor Air Quality Expert at ET&T, Call 760-804-9400 or
Click Here for A Free Consultation.
|